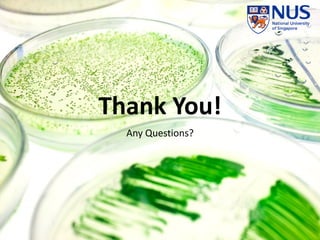
Thank You!
Any Questions?

The document discusses the potential of algae biofuels as a sustainable alternative to fossil fuels, highlighting their high yield, low environmental impact, and ability to grow on non-arable land. It covers the production process, costs, improvements, and entrepreneurial opportunities within the algae biofuel sector. Despite its promise, the document notes economic barriers and the need for subsidies to make algae biofuels competitive with traditional fuels.